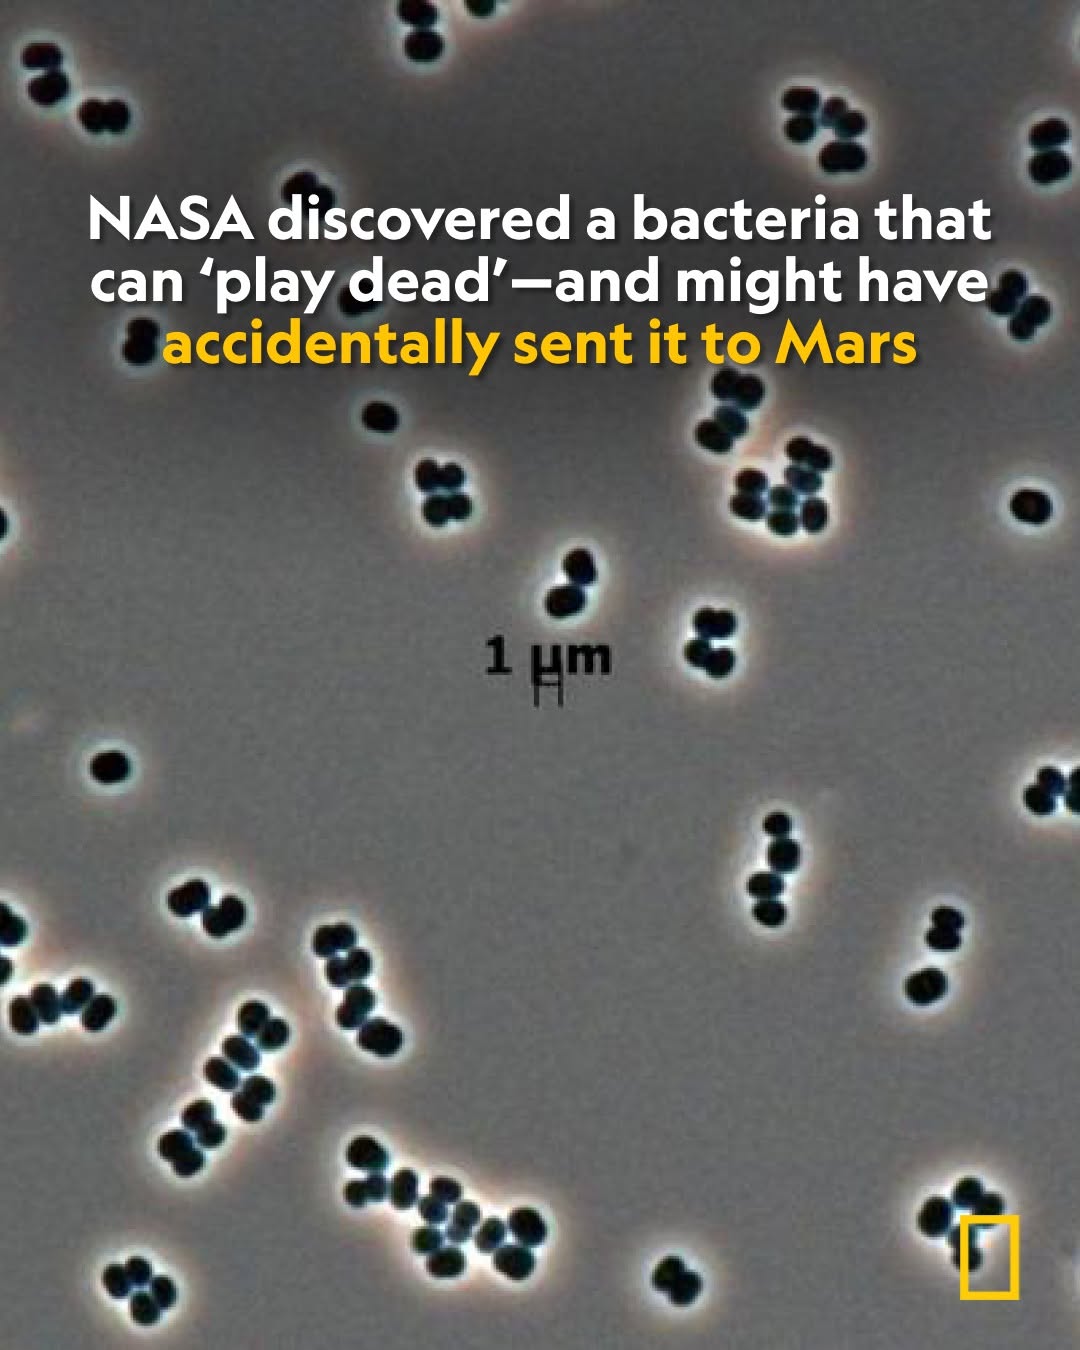

This is an overview of all the widgets we offer ✨ we’re continuously adding new ones.
🔎 Search: Use CTRL+F
💌 Help? support@bento.me
Smart Widgets - Engineering Platforms: Github 🧑🏻💻
Smart Widgets - Social Platforms: Instagram and Twitter 😇
Smart Widgets - Design Platforms: Dribbble, Figma and Behance 🎨
Smart Widgets - Entertainment Platforms: YouTube and TikTok 🎥
You can add Text: Notes, Quotes, Testimonials or Customer Reviews 📝
You can choose from different widget sizes 🙆🏼♀️
That's it for now ✨
You can add any link there is 🤗 🔗 oh and btw, I'm a Section title 👋🏻
We turn some platforms into Smart Widgets for you ✨
Smart Widgets - Audio Platforms: Spotify 🎶
You can add images and videos ❤️🔥
I'm a video - I autoplay & loop
I'm a large image.
I'm a tall image.
Smart Widgets - Map 🗺